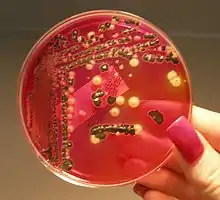

إنتان
الإنتان أو تعفن الدم[2] أو خمج الدم[2](بالإنجليزية: septicemia أو sepsis) هي مصطلحات مترادفة تشير إلى حالة مرضية خطيرة عند الإنسان والحيوان تتميز بتفاعل التهابي معمم نتيجة عدوى جرثومية وظهور جراثيم ونواتج استقلابها في الدم والأنسجة، مما يؤدي إلى تعفن الدم. أشيع مسببات الإنتان هي العنقوديات والعقديات، وأندر منها المكورات الرئوية والإشريكيات القولونية. وقد تم استخدام هذه التسميات بشكل غير متسق في الماضي من قبل أصحاب المهن الطبية، على سبيل المثال كمرادف للتجرثم (أو الإنتان البكتيري)، مما تسبب في بعض الارتباك.
| إنتان | |
|---|---|
| معلومات عامة | |
| الاختصاص | أمراض معدية |
| من أنواع | التهاب عام ، ومرض شامل |
| الأسباب | |
| عوامل الخطر | عدوى [1] |
| المظهر السريري | |
| الأعراض | remittent fever ، ونفضان ، وحمى متقطعة |
| الإدارة | |
| أدوية | سيفترياكسون ، وميزلوسيللين ، ونافسيلين ، وسيفيبيم ، وسيفوتيتان ، وأوكساسيلين ، وتيكارسيلين ، وأميكاسين ، وأزتريونام ، وإيميبينيم ، وجنتاميسين ، وسيفوتاكسيم ، وسيفتيزوكسيم ، وإيرتابينيم ، وبايبيرسيلين ، وسيفتازيديم ، وسيفوكسيتين
|
| التاريخ | |
| وصفها المصدر | قاموس بروكهاوس وإفرون الموسوعي |
وقد أظهرت الدراسات السريرية إلى أن حالات تسمم الدم قد تكون مستمرة أو متقطعة.[3]
يحدث تسمم الدم المستمر في المقام الأول في المرضى الذين يعانون من التهابات الأوعية الدموية (مثل التهاب الشغاف والتهاب الوريد الخثاري المنتن (en) والالتهابات المرتبطة قسطرة الأوعية الدموية)، أو مع حالات تعفن الدم العظمى (الصدمة الإنتانية على سبيل المثال).
تسمم الدم المتقطع يحدث في المرضى الذين يعانون من التهابات موضعية (على سبيل المثال: الرئتين والمسالك البولية والجلد والأنسجة الرخوة).[3][4]
التهابات مجرى الدم
عدوى مجرى الدم (أو الإنتان البكتيري) هو وجود بكتيريا في الدم [3] والتي قد تكون عابرة ودون أعراض.[5] ووفقاً لمراكز مكافحة الأمراض واتقائها (CDC)، يمكن تعريف عدوى مجرى الدم بانها وجود بكتيريا قادرة على البقاء في الدم (أي تجرثم الدم) ومثبتة باستنبات دم (en) إيجابي.[6] يتم الكشف عن البكتيريا في الدم باستنبات الدم. وعادة ما يقصد بالإنتان البكتيري بوجود بكتيريا حية قادرة على البقاء في مجرى الدم.
وترتبط عدوى مجرى الدم مع ارتفاع معدلات الاعتلال والوفيات. في الولايات المتحدة يقدر مرضى التهابات مجرى الدم بحدود 250000 حالة في السنة. يتم اكتساب العديد من حالات العدوى في المستشفيات. التهابات مجرى الدم واحدة من الأسباب العشر الرئيسية للوفاة، معدل الوفيات تتراوح بين 12٪ في حالات المستشفيات إلى 80٪ في وحدة العناية المركزة.[6][7]

التصنيفات التهابات مجرى الدم
صنفت التهابات مجرى الدم إلى ثلاث فئات وفقاً لتصنيف فريدمان وآخرين (Friedman et al.).[8][9]
- التهابات مجرى الدم المكتسبة بالمستشفيات: استنباتات الدم الإيجابية يحصل عليها من المرضى أمضوا فترة 48 ساعة فعلية أو أكثر في المستشفيات.
- التهابات مجرى الدم المرتبطة بالرعاية الصحية: استنباتات الدم الإيجابية التي يحصل عليها في غضون 48 ساعة أو إذا كان المريض قد تلقى علاج بالقسطرة الوريدية في المنزل، وكان قد حضر مستشفى أو عيادة غسيل الكلى أو تلقى العلاج الكيميائي عن طريق الوريد أو أدخل المستشفى خلال الثلاثة أشهر السابقة، أو كان مقيما في دار تمريض (en).[9]
- التهابات مجرى الدم المكتسبة من المجتمع: استنباتات الدم الإيجابية يحصل عليها في غضون 48 ساعة من دخول المستشفى، للمرضى الذين لا يحملون معايير التهابات مجرى الدم المرتبطة بالرعاية الصحية.[8][9]
تعرف التهابات مجرى الدم المؤكدة مختبريا بأنها استنباتات الدم الإيجابية لممراض يلاحظ في استنبات دم واحدة أو أكثر، وليس للإصابة أية علاقة بإصابة في موقع آخر من الجسم. في حالة وجود الملوثات الجلدية الشائعة بدلاً من أن يكون ممراض الملاحظ، فإن التعرف على الإصابة يكون من خلال الحصول على نتيجة إيجابية من مجموعتين أو أكثر إما من استنباتات الدم المسحوبة من أماكن مختلفة من مريض الحمى أو من مجموعة واحدة من الاستنباتات التي أخذت من مريض مصاب يعالج بالمضادات الحيوية المناسبة عن طريق الوريد.[6]
موقع الإصابة قد يكون بولياً أو داخل البطن أو بسبب قسطرة الأوعية الدموية أو رئوي أو الجلد والأنسجة الرخوة أو عدوى مجرى الدم الابتدائي أو غير معروف تبعاً لتعريفات مراكز مكافحة الأمراض واتقائها.[4][8]
أيضاً يمكن أن تصنف التهابات مجرى الدم وفقاً لشدة الأمراض الكامنة، يمكن تصنيف المرضى إلى واحد من ثلاث فئات وفقاً لتصنيف مكابي وجاكسون وهي:[4]
- الوفاة سريعاً
- الوفاة في نهاية المطاف
- غير مميتة
يصنف المرضى الذين يستخدمون الأدوية المثبطة للمناعة والمرضى الذين يعانون من عدوى فيروس العوز المناعي البشري أو قلة العدلات (أقل من 1000 خلية عدلة في الملمتر المكعب) بأنهم ضعيفو المناعة (en).[4]
مصدر التهابات مجرى الدم
تصنف التهابات مجرى الدم إلى أولية (أو أساسية) وثانوية تبعاً لمصدر العدوى. الأجهزة الوريدية هي المصدر الأكثر شيوعاً لالتهابات مجرى الدم. عدوى المسالك البولية (en)هو المصدر الثاني الأكثر شيوعاً.[4][9]
ويمكن تمييز التهابات مجرى الدم الأولية (أي أنها بدون مصدر سابق من حالات العدوى) عن التهابات مجرى الدم الثانوية (أي أنها ناتجة من عدوى أخرى، مثل ذات الرئة والتهاب المسالك الصفراوية وعدوى الجلد والأنسجة الرخوة وعدوى الجرح).[4]
مراكز مكافحة الأمراض واتقائها (CDC) يقسم التهابات مجرى الدم الأولية إلى:
- التهابات مجرى الدم المؤكدة مختبرياً
- إنتانات سريرية.[4]
المرضى الذين يعانون من التهابات مجرى الدم المكتسبة بالمستشفيات والتهابات مجرى الدم المرتبطة بالرعاية الصحية يصابون بإنتانات بكتيرية سببها الأجهزة الوريدية أو الجهاز الهضمي أو الجلد والأنسجة الرخوة (مثل عدوى قرحة الفراش وحالات التهاب النسيج الخلوي (en))، وهذه الأسباب احتمالاتها متقاربة، أما المرضى الذين يعانون من التهابات مجرى الدم المكتسبة من المجتمع فهم معرضون أكثر لالتهابات مجرى الدم الثانوية التي سببها عدوى المسالك البولية.[4][9][10]
الإنتان البكتيري
الإنتان البكتيري أو تجرثم الدم هو وجود بكتيريا في الدم. ويتم الكشف عن البكتيريا في الدم باستنبات الدم. تجرثم الدم هو وجود البكتيريا قادرة على البقاء في مجرى الدم.
قد يكون التجرثم أول دليل على وجود إصابة بمرض كامن خطير، مثل فيروس متلازمة العوز المناعي المكتسب أو خبيثة الدم (en) أو خبيثة en) الأجهزة الصلبة.[6]
التجرثم العابر قد يستمر لدقائق أو بضع ساعات، وغالباً يحدث بعد التلاعب بمواقع الجسم غير معقمة بعد العمليات مما تؤدي إلى تلوث الجلد أو الأسطح المخاطية وأيضاً في بداية الالتهابات البكتيرية الحادة.[6]
أما التجرثم المتقطع فهو تجرثم بسبب الكائنات الحية الدقيقة نفسها التي تم الكشف عنها بشكل متقطع في نفس المريض بسبب وجود دورة التخليص وتكرارها.[6]
أما تجرثم الدم المستمر فهو الصفة المميزة لالتهاب الشغاف والتهابات الأوعية الدموية الأخرى. تجرثم الدم المستمر يحدث خلال المراحل المبكرة من العدوى البكتيرية الجهازية، مثل الحمى المتموجة وحمى التيفوئيد.[6]
تعريفات ومصطلحات متعلقة بالإنتان
الإنتان هو الحالة التي تتوفر في الشخص مواصفات متلازمة الإستجابة الإلتهابية الجهازية (SIRS) ويكون مصاباً بعدوى مشخصة أو مشتبه بشدة بإصابته بها. ويتميز الإنتان بحالة التهاب كامل الجسم. قد تظهر على الجسم أعراض الاستجابة الالتهابية للإنتان بواسطة استجابة الجهاز المناعي للميكروبات في البول أو الدم أو الرئتين أو الجلد أو الأنسجة الأخرى. وهناك مصطلح آخر يستخدم للإنتان هو تسمم الدم. الإنتان الحاد هو الاستجابة الالتهابية الجهازية، بالإضافة إلى عدوى بالإضافة إلى وجود فشل عضو (en) في الجسم.[11][12]
متلازمة الإستجابة الإلتهابية الجهازية (SIRS) هي حالة للالتهابات التي تؤثر على الجسم كله، وكثيراً ما يكون هنالك رد فعل من الجهاز المناعي للعدوى، ولكن ليس بالضرورة.
يعرف الإنتان الحاد بأنه إنتان مصاحب بفشل عضو أو نقص انسياب الدم أو انخفاض ضغط الدم.
متلازمة الاستجابة الالتهابية الجهازية
أعراض متلازمة الاستجابة الالتهابية الجهازية (Systemic inflammatory response syndrome) تشمل، ولكنها لا تقتصر على:
- درجة حرارة الجسم (en) أقل من 36° درجة مئوية أو أعلى من 38° درجة مئوية
- معدل ضربات القلب أعلى من 90 نبضة في الدقيقة
- تسرع النفس (en) بمعدل أكثر من 20 نفساً في الدقيقة أو ضغط جزئي شرياني لغاز ثنائي أكسيد الكربون أقل من 4.3 كيلو باسكال (32 ملم زئبقي)
- تعداد خلايا الدم البيضاء أقل من 4000 خلية/ملم³ أو خلايا أكثر من 12,000 خلية/ملم³، أو وجود أكثر من 10٪ من العدلات غير الناضجة (خلية الشريط (en)).
ويمكن تشخيص متلازمة الاستجابة الالتهابية الجهازية عند وجود اثنين أو أكثر من الأعراض أعلاه.[11][12]
الصدمة الإنتانية
مقالة مفصلة: صدمة إنتانية
الصدمة الإنتانية هي حالة طبية طارئة بسبب انخفاض التروية الأنسجة وتزويد الأوكسجين نتيجة لعدوى شديدة وإنتان، على الرغم من أن عدوى الجرثومة قد تكون منتشرة في الجسم أو محددة في مكان أو عضو معين في الجسم. يمكن للصدمة الإنتانية أن تتسبب بمتلازمة فشل الإعضاء المتعددة (en) (المعروف سابقاً باسم الفشل العضوي المتعدد) والموت.[11][12]
ضحاياه الأكثر شيوعاً هم:
- الأطفال
- المصابون بنقص المناعة
- المسنين
عادة، تتم رعاية المرضى الذين يعانون من الصدمة الإنتانية في وحدات العناية المركزة. معدل وفيات الأطفال من الصدمة الإنتانية ما يقرب من 25٪-50٪.[11][12]
الإنتان الوليدي
الإنتان الوليدي (Neonatal sepsis) هو نوع من تعفن الدم يشير تحديداً إلى وجود عدوى بكتيرية في الدم (التهابات مجرى الدم)، مثل التهاب السحايا والالتهاب الرئوي والتهاب الحويضة والكلية، أو التهاب المعدة والأمعاء المصاحبة للحمى.
أعراض الدورة الدموية أو فشل الجهاز التنفسي ليست مفيدة سريرياً لأن هذه الأعراض في كثير من الأحيان لا تنشأ في حديثي الولادة حتى يوشك الطفل على الموت ولا يمكن منعه.[11][12]

الممراضات المسببة للإنتان
البكتريا سلبية الغرام وخاصة من عائلة البكتيريا المعوية (مثل السلمونيلا) هي السبب الرئيسي للإنتان البكتيري.[10] حالياً في البلدان المتقدمة، تشخص البكتيريا إيجابية الغرام في كثير من الأحيان أكثر من السالبة في التهابات مجرى الدم في مرضى السرطان. ولكن في البلدان النامية هذا التحول غير موجود بسبب شحة مصادر السيطرة على العدوى.[10]
الدراسات تختلف في مسببات الإنتان فيم إذا كانت البكتيريا إيجابية الغرام أو البكتريا سلبية الغرام هي الغالبة.
بصورة عامة فإن أكثر أنواع البكتريا المسببة للإنتان هي:[10]
الإنتان الفطري محدود مقارنة بالإنتان البكتيري، لكن السبب الرئيسي له هو الكانديدا (Candida) والمعروفة بأنها المسببة لمرض داء المبيضات.
المضادات الحيوية
لعلاج الإنتان، ينبغي أن يستند اختيار الأدوية على المصدر المحتمل للعدوى و نوع صبغة غرام الظاهرة في مسحة العينات السريرية المناسبة والحالة المناعية للمريض. وينبغي أن يكعس الاختيار أيضاً الأنماط المحلية لمقاومة المضادات الحيوية.[13]
يمكن استخدام الجيل الثالث والرابع من السيفالوسبورينات أو البيبيراسيلين/تازوباكتام أو التيكارسيلين/كلافولانات أو الأميبينيم أو الميروبينيم أو الأزتريونام لعلاج تعفن الدم الناجم عن معظم سلالات العصيات سلبية الغرام. السيفتازيديم أقل نشاطا ضد مكورات إيجابية الغرام. السيفالوسبورينات الأخرى من السيفتازيديم والسيفيبيم لها نشاط محدود ضد الزائفة الزنجارية. البيبيراسيلين/تازوباكتام وتيكارسيلين/كلافولانات والأميبينيم والميروبينيم تعتبر أدوية فعالة ضد معظم سلالات الزائفة الزنجارية وفعالة أيضاً ضد اللاهوائيات. الأزتريونام فعال ضد العديد من سلالات الزائفة الزنجارية ولكن ليس له فعالية ضد الجراثيم الإيجابية الغرام أو اللاهوائيات.[13]
العلاج الأولي للبالغين الذين حياتهم في خطر بسبب الإنتان، فإن مستشاري مؤسسة الرسالة الطبية (en) يوصون باستخدام الجيل الثالث والرابع من السيفالوسبورينات أو البيبيراسيلين/تازوباكتام أو الأميبينيم أو الميروبينيم بالإضافة إلى أمينوغليكوزيد. عندما تشتبه الإصابة بعدوى العنقوديات الذهبية المقاومة للمثسلين أو بكتريا (Staphylococcus epidermidis) مقاومة للميثيسيلين فيضاف في كثير من الأحيان الفانكوميسين وحده أو مع جنتاميسين أو ريفامبسين (أحدهما أو كلاهما). عندما تشتبه الإصابة بالتهاب الشغاف الجرثومي فيجب بدء العلاج قبل أن يتم التعرف على العوامل المسببة للأمراض، ويمكن استخدام مزيج من سيفترياكسون وفانكوميسين، بعض الاستشاريين مؤسسة الرسالة الطبية ينصحون بإضافة الجنتاميسين أيضاً.[13]
إنتان الدم المكتسب من المجتمع
في هذه الحالة يقترح استخدام البنسلينات واسعة الطيف (en) أو السيفالوسبورينات واسعة الطيف. إذا اشتبهت الإصابة بالعنقوديات الذهبية المقاومة للمثسلين فينبغي إضافة فانكوميسين. إذا اشتبهت عدوى اللاهوائيات، ينبغي أن يضاف الميترونيدازول إلى السيفالوسبورينات واسعة الطيف. أما إذا اشتبت الإصابة بكائنات دقيقة أخرى مقاومة فينبغي استخدام مضاد حيوي أوسع طيفا من مجموعة البيتا لاكتام المضادة للبكتيريا (en) (الميروبينيم مثلاً).[14]
إنتان الدم المكتسب من المستشفيات
في هذه الحالة يقترح استخدام البنسلينات واسعة الطيف (البيبيراسيلين/تازوباكتام أو التيكارسيلين/كلافولانات) أو السيفتازيديم أو الأميبينيم مع السيلاستاتين أو الميروبينيم. إذا اشتبهت الإصابة بعدوى العنقوديات الذهبية المقاومة للمثسلين فيجب إضافة الفانكوميسين. إذا اشتبه عدوى ببكتريا لا هوائية فجيب إضافة الميترونيدازول إلى السيفالوسبورينات واسعة الطيف.[14]

إنتان الدم نتيجة قسطرة الأوعية الدموية
في هذه الحالة يقترح استخدام الفانكومايسين. أما إذا اشتبهت حالة إنتان بواسطة بكتريا سالبة الغرام، وخاصة في مرضى نقص المناعة، فيجب إضافة مضاد حيوي من مجموعة البيتا لاكتام المضادة للبكتيريا واسعة الطيف ويجب إزالة قسطرة الأوعية الدموية، وخاصة إذا سبب العدوى عن طريق المكورات العنقودية الذهبية أو الزائفة أو المبيضات (الكانديدا).[14]
إنتان التهاب السحايا
إذا اشتبه إنتان التهاب السحايا (Meningococcal septicaemia) فيمكن إعطاء جرعة واحدة مستعجلة من بنزيلبنسين قبل نقل المريض للمستشفى ما دام ذلك لا يؤخر نقله؛ سيفوتاكسيم قد يكون بديلاً في حالة حساسية البنسلين، يمكن استخدام الكلورامفينيكول إذا كان المريض يشكو من فرط الحساسية للبنسلين والسيفالوسبورينات. وللقضاء على النقل البلعومي، يجب أن تعطى الريفامبيسين لمدة يومين.[14]
الإنتان في العالم
الإنتان في أفريقيا
العدوى الأولية (على سبيل المثال، الجهاز التنفسي، والمسالك البولية، أو الجهاز الهضمي) غالبا ما تؤدي إلى عدوى مجرى الدم (BSI) ويمكن أن تسبب الحمى. وبالتالي، قد تسهل معالجة المريض المصاب بالحمى الراقد في المستشفى مريضا الحموية بالكشف عن عدوى مجرى الدم. ولكون الدم هو موقع عقيمة عادة، فإن استنبات الدم المناسب له القيمة مهمة، لكنه من الصعب تشخيص عدوى مجرى الدم في البلدان النامية، حيث خدمات التشخيص الميكروبيولوجي قد تكون محدودة أو غائبة. في أفريقيا جنوب الصحراء، يرتفع معدل انتشار فيروس العوز المناعي البشري-نوع1 وتشح مصادر البايولوجية لذلك فإن عدداً من الممراضات التي تسبب عدوى مجرى الدم قد لا تكتشف.[15]
ان دراسات سابقة في أفريقيا جنوب الصحراء الكبرى نتائج متضاربة بشأن الأهمية النسبية لبكتريا (Mycobacterium tuberculosis) وStreptococcus pneumoniae والسلمونيلا غير التيفية في كونها أسباباً لعدوى مجرى الدم.
طالع ايضا
المصادر
- https://www.sepsis.org/sepsis-basics/risk-factors/
- قاموس المورد، البعلبكي، بيروت، لبنان.
- Murray PR, Rosenthal KS, Pfaller MA. Medical Microbiology. 6th ed. Canada: Mosby Elsevier, 2009.
- Seifert H. The Clinical Importance of Microbiological Findings in the Diagnosis and Management of Bloodstream Infections. Clinical Infectious Diseases 2009; 48:S238–245
- Shah Siddharth N. Text Book of Medicine. The association of physicians of India; 1999.
- Sanders J, Pithie A, Ganly P, Surgenor L, Wilson R, Merriman E, Loudon G, Judkins R, Chambers S. A prospective double-blind randomized trial comparing intraluminal ethanol with heparinized saline for the prevention of catheter-associated Blood-stream infection in immunosuppressed haematology patients. Journal of Antimicrobial Chemotherapy 2008; 62:809–815.
- Bassetti M, Ginocchio F, Giacobbe DR. New approaches for empiric therapy in Gram-positive sepsis. Minerva Anestessiologia. 2011; 77:821-827.
- Daikos GL, Petrikkos P, Psichogiou M, Kosmidis C, Vryonis E, Skoutelis A, Georgousi K, Tzouvelekis LS, Tassios PT, Bamia C, Petrikkos G. Prospective Observational Study of the Impact of VIM-1 Metallo--Lactamase on the Outcome of Patients with Klebsiella pneumoniae Blood-stream Infections. Antimicrobial Agents And Chemotherapy, May 2009, P. 1868–1873
- Friedman ND. Health care-associated Blood-stream infections in adults: a reason to change the accepted definition of community-acquired infections. Annals of Internal Medicine. 2002; 137:791–797.
- Kurtaran B, Candevir A, Tasova Y, Kibar F, Inal AS, Yavuz S, Kara O, Gurkan E, Paydas S, Aksu H, Seyadaoglu G. Hospital-Acquired Blood-stream Infections in Cancer Patients between 2005 and 2007 in a Turkish University Hospital. Archives of clinical microbiology. 2010; 1:2-4.
- Sepsis and Septic Shock. In: Fauci AS, Braunwald E, Kasper DL, Hauser SL, Longo DL, Jameson JL, Loscalzo J, editors. Harrison's Manual of Medicine. The McGraw-Hill Companies, 2009. p. 63-66.
- بحث ماجستير غير منشور:Mahmood Majid Salman. A PROSPECTIVE STUDY OF BACTERIAL RESISTANCE AND SENSITIVITY IN SEPTICEMIC PATIENTS. 2012
- Abramowicz M., editor. Handbook of Antimicrobial Therapy, 17th Ed. New Rochelle (NY): The Medical Letter Inc.; 2005.
- Infections. In: BNF for Children 2011-2012. Pharmaceutical Press. Basingstoke (UK), 2011. p.297
- Lennox K. Archibald, L. Clifford McDonald, Okey Nwanyanwu, Peter Kazembe, Hamish Dobbie, Jerome Tokars, L. Barth Reller, and William R. Jarvis. A Hospital-Based Prevalence Survey of Bloodstream Infections in Febrile Patients in Malawi: Implications for Diagnosis and Therapy. The Journal of Infectious Diseases 2000;181:1414–20
- Svenja J. Albrecht, Neil O. Fishman, Jennifer Kitchen, Irving Nachamkin, Warren B. Bilker, Cindy Hoegg, Carol Samel, Stephanie Barbagallo, Judy Arentzen, Ebbing Lautenbach. Reemergence of Gram-negative Health Care–Associated Bloodstream Infections. Arch Intern Med. 2006;166:1289-1294
- بوابة طب
_PAS_stain.jpg.webp)